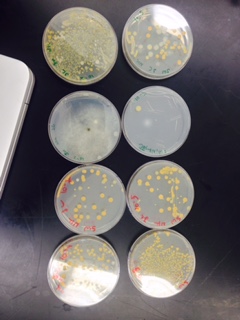

User:Jose Valentin Camilion/Notebook/Biology 210 at AU
Invertebrates and Vertebrates July 19th
Introduction
The purpose of the Transect Lab is to observe the biodiversity within a selected transect. In this portion of the lab, Invertebrates are collected from the Berlese funnel that contained leaf litter from the transect. Invertebrates are animals that do not possess a vertebrate column. Most invertebrates are arthropods. Ecologically speaking, many soil animals are predators. Additionally, vertebrates from the selected transect will also be recorded, for they as well partake in the observed community.
Methods
The experiment began by observing the acoelmate, Planaria. The Planaria were observed for their movements. Once their movements were observed, the organisms from the Berlese Funnel were retrieved. The liquid, which contained the organisms, was gently poured onto a petri dish. The organisms from the petri dish were observed individually, having placed each of them on a slide, under a dissecting microscope. The organisms were identified by using a website with an Insecta Key by matching their physical characteristics. Furthermore, the organisms’ size were then measured. Once the data from each organism was collected, all the materials were cleaned and put away. Lastly, the transect was revisited so that the vertebrates present can be observed, identified, and recorded.
Results
There were several different organisms on the Berlese funnel. At least five different organisms were observed, with four of them identified. The last organism shown in figure 5 remained unidentified, because it's characteristics were not similar to any of the organisms on the Insecta Key.
Table 1 shows a chart with the recorded observations of the specimen found, as well as their identities.
Figure 1 shows a plate with the insects that were collected by the Berlese Funnel.
Figure 2 shows an Arthropoda Chlipoda (Superpede)
Figure 3 shows an Arthropoda Diplopoda (Millipede)
Figure 4 shows an Arthropoda Cleoptera
Figure 5 shows an Arthropoda Hymenopetra (Formicida)
Figure 6 was unidentified
Table 2 shows the Vertebrate organisms in the transect
Figure 7 shows a food web made by Noy Kaufman
Discussion
In just a single collection of leaf litter, at least five different organisms were observed. This accounts for a small portion of a 20 X 20 meter transect. Each organism plays a role in the transect as predators, where they suck fluids from roots, consume fungi, and feast on decaying plant material. All help in breaking down and recycling decomposing plant and animal material. Additionally, the vertebrates play a role in their community just as well, whether they are predators of these insects, or whether they become their food when they are dead.
References
Bentley, M., Walters-Conte, K., Zeller, N. 2015. A Laboratory Manual to Accompany General Biology II. American University Department of Biology.
Plantae and Fungi July 9th
Introduction
American University is a great campus when it comes to plant diversity. The whole campus is one big garden that contains several angionsperm plants, meaning flowering plants. Angiosperms spread their gametes, which in this case pollen, via wind borne mechanisms and consequently radiate into many niches. So far, in lab, transects at AU have been studies, so in this particular lab, the angiosperms from the transect that has so far been examined will be observed and characterized as a way to look at the amount of plant diversity that occurred through the fertilization of the several plants.
Methods
The lab began by obtaining ziplock bags and going to the transect from the first experiment, which is the lawn behind Hurst. First, a lead litter sample from the transect was collected, where the entire bag was filled with leaves. The leaves collected were exclusively leaves that have already fallen on the ground. These leaves will be used for the berlease funnel for the next lab. After the bag was full, a second bag would then contain different flowers from angiosperm plants. The flowers would then be studied for their characteristics, and based on those characteristics, they would be compared to the flowers in an i-phone app Leafsnap. Once the flowers were identified, and their characteristics recorded, the Berlese funnel to collect the invertebrates was set up. 25 mL of 50:50 ethanol/ water solution into a 50 conical tube was placed. Screening material was placed at the bottom of a funnel. The leaf litter collected was placed onto the funnel and the funnel was taped onto the conical tube. The complex was placed under a 40 watt lamp above the funnel. This would be left there until the next lab period.
Results
Figure 1 shows a Paper Birch plant
Figure 2 shows a Trifolium Repens plant
Figure 3 shows a Hibiscus plant
Figure 4 shows Malvs Hupeheasis plant
Figure 5 shows a Crategus Gus Galli plant
Table 1 shows an upside down chart of the characteristics of the plants found
Discussion
There is an evident amount of diversity in just a single transect. It should be noted that although there is clear diversity, there were even more plants in the transect, which shows just how diverse the community can be. The different characteristics of the flowers have different characteristics that aid in their lifestyle. Additionally, their characteristics allow for symbiotic relationships with other animals. During the flower picking, it was observed that a bee was inside a flower picking nectar, which the flower would then take advantage to leave pollen on the bee so that it may reproduce elsewhere.
References
Bentley, M., Walters-Conte, K., Zeller, N. 2015. A Laboratory Manual to Accompany General Biology II. American University Department of Biology.
Microbiology and Identifying Bacteria with DNA Sequences July 7th
Introduction
In the previous lab, unicellular organisms from the Eukarya were being observed. In this lab, the organisms that perhaps inhibit most of the Earth will be observed, which are the prokaryotes that are grouped in the domain bacteria. There are different ways that microorganisms can be classified and identified; the traditional method is based on cell morphology. The shapes of the bacteria may be studied under this method, of which early studies outline three shapes: bacillus (rod-shaped), coccus (spherical), and spirillum (twisted spiral). Another method for differentiating microorganisms is by their staining characteristics. The most common stain for bacteria is the gram stain, of which they are either gram positive—have a thick layer of peptidoglycan in their cell walls; or they are gram negative—have less peptidoglycan. Whether or not they are gram positive depends on the stains that they give out, with blue meaning positive and negative being pink (Bentley 2015. The purpose of this lab is to classify the bacteria organisms based on the characteristics that are observed.
Methods
The lab commenced by making a last observation of the Hay Infusion Culture. Once the observations were recorded, the lab proceeded observe the agar plates, of which there were eight. There were four diluted nutrients which also contained the antibiotic tetracycline, and four diluted nutrients. The colonies grown on the agar plates were observed and counted, and recorded. After the bacteria are counted, four slides are prepared—two from the agar plates with the nutrient and two from the tetracycline agar plate. The two that were picked out for each were from the 10-3 dilution and from the 10-9 dilution. With these slides, the gram stain procedure began. A drop of water was added to each of the slides, and were then sterilized over a flame until it was visibly clear that the water had evaporated. Once all the slides had been passed over the flame, the bacterial smear is covered with crystal violet for one minute. The crystal violet is then rinsed with water. The bacterial smear was then covered with Gram’s iodine mordant for one minute. The iodine was then rinsed with water. The smear was then decolorized by flooding the bacterial smear with 95% alcohol for about fifteen seconds. Furthermore, the smear was covered with safranin stain for about twenty five seconds. The stain was rinsed with water. The gram stained sample was then observed under a microscope at a low magnification and then observed under 40X objectives. Any characteristics observed were recorded. Finally, for the PCR for the next lab was set up by transferring a single colony was transferred into 100 µL of water into a sterile tube.
Results
Having observed the Hay Infusion environment, it was evident that there were a few changes, such as the jar having being clearer, with plants on the bottom. The smell was still foul and may be compared with the smell of a dirty sink.
Figure 1 Nutrient and Nutrient + tetracycline Agar plates
Figure 2
Table 1 100-fold serial dilution results
Table 2 Characterization of Bacteria
Discussion
The observations of the agar plates were that all of the colonies were circular, except for one nutrient agar plate with 10^-9 had a lawn. Most of the colonies observed were orange, and the sizes of those colonies varied from each agar plate, as well as the amount present. There was no consistent difference between the nutrient plate and the tetracycline plate as the serial dilutions changed. However, it is evident that on average, the tetracycline Agar plate had more bacteria counter than the nutrient plate.
References
Bentley, M., Walters-Conte, K., Zeller, N. 2015. A Laboratory Manual to Accompany General Biology II. American University Department of Biology.
Identifying Algae and Protists July 2nd
Intro
The purpose of this lab was to identify protists using the dichotomus key, which consist of two morphological choices. This was possible through the microscope, which through it’s use made it possible to observe specimens that would otherwise not be visible to the human eye. With a visible specimen, one may then know what kind of specimen is present by identifying it’s key characteristics. The Dichotomus key is a tool that offers the characteristics that certain organism have, which my then be used to determine what kind of specimen is being observed.
Methods
The jar with the Hay Infusion was observed for characteristics such as smell and appearance. Two different samples were collected from the jar, which were two different niches of the jar. One of the samples was from the top of the jar, and the second was from the bottom of the jar. Furthermore, two wet mounts for both of the samples were prepared and were looked at under a microscope. The organisms that were visible under the microscope were observed for their characteristics so that they may be identified. By looking at the characteristics, the Dichotomus Key would specify which organism would have the charactersitics that were observed. Additionally, for the next lab, a serial dilution was made. Four test tubes were used, each containing 5 mLs of series broth were labled 10^-2, 10^-4, 10^-6, 10-^8. Furthermore, 50 μL of the hay infusion jar was collected and placed in the 10^-2 test tube. The test tube was mixed, and then 50 μL of that test tube was placed onto the 10^-4 test tube. This continued until the 10^-8 test tube. Additionally, four nutrient plates were labeled as 10^-3, 10^-5, 10^-7, 10^-9. From the test tube of the 10^-2 content, 100μL was retrieved and added to the 10^-3. A sterile stick was used to spread the content onto the nutrient plate. Similarly, 100μL of the content from the 10^-4 was added to the 10^-5 nutrient plate. The steps continued for the nutrient plates and their respective test tubes.
Results
The Hay infusion jar had a foul smell. There were observable mold brown spots on the surface of the liquid, which means that organisms are clearly present in the jar. Most of the mixture was cloudy and murky and while about a fourth of the jar had a thick layer of dirt in the bottom of the jar, which also contains some grass.
Figure 1 shows Euglena observed under 10X magnification
Figure 2 shows Chlamydomonas observed under 40X magnification
Figure 3 shows Didinium observed under 40X magnification
Discussion
The purpose of this experiment was to identify the protists present in the hay infusion environment. Only three different organisms were present, which may make for an inaccurate representation of the transect. It could, however, also mean that the transect does not work well with algae and protists, which is why there was a low number visible. Improvements that could be made to identify more organisms are to leave the hay infusion sitting for more time so that there could be more growth taking place in the environment.
References
Bentley, M., Walters-Conte, K., Zeller, N. 2015. A Laboratory Manual to Accompany General Biology II. American University Department of Biology.
Examining Biological Life at AU June 30th
Intro
A transect is used in this experiment to make a study on the ecological components in American University. A transect is a sample of an ecosystem. The transect may consist of both the biotic, which are the living components present such as plants and insects, as well as abiotic, which may include soil and stone. The biodiversity that is present in these communities are a result of natural selection, which occurs by gene flow, mutations, and genetic drifts.
Methods
In this experiment, the transect observed was a lawn in American University that is behind the Hurst building. The transect was measured in 20 x 20 meters, and it was then observed closely. With a chosen transect, the experiment proceeded to identifying the biotic and abiotic factors present. A sample of the transect was selected, which was soil and grass, and was then placed into plastic bag. From that bag, 12 grams of the sample was placed into a jar along with 500 grams of deerpark water. Additionally , 0.1 grams of powdered milk were added to the jar. The jar was then shaken thoroughly for 10 seconds. The jar would then sit in the lab until the class met again two days later.
Results
The transect was mostly composed of grass and trees. The biotic factors present grass, trees, flowers, fungi, bees, flies, worms, birds, and squirrels. The Abiotic factors present were soil, water, air, light, statues, lams, and sprinklers. The transect was also next to a side walk and a road, where many people pass walking and by car respectively.
Figure 1 shows a map of the transect
Figure 2 shows the transect
Discussion
The purpose of this experiment was to select a transect for some of the upcoming experiments. This experiment identified the biotic factors, such as the grass, trees, flowers, and bees; as well as the abiotic factors, such as air, water, soil, and rocks. Knowing the factors that are present are important so that the ecosystem can be better understood in terms of its composure. The hay infusion was also important for the necessary so that the organisms may grow and may be observed in the following experiment.
References
Bentley, M., Walters-Conte, K., Zeller, N. 2015. A Laboratory Manual to Accompany General Biology II. American University Department of Biology.